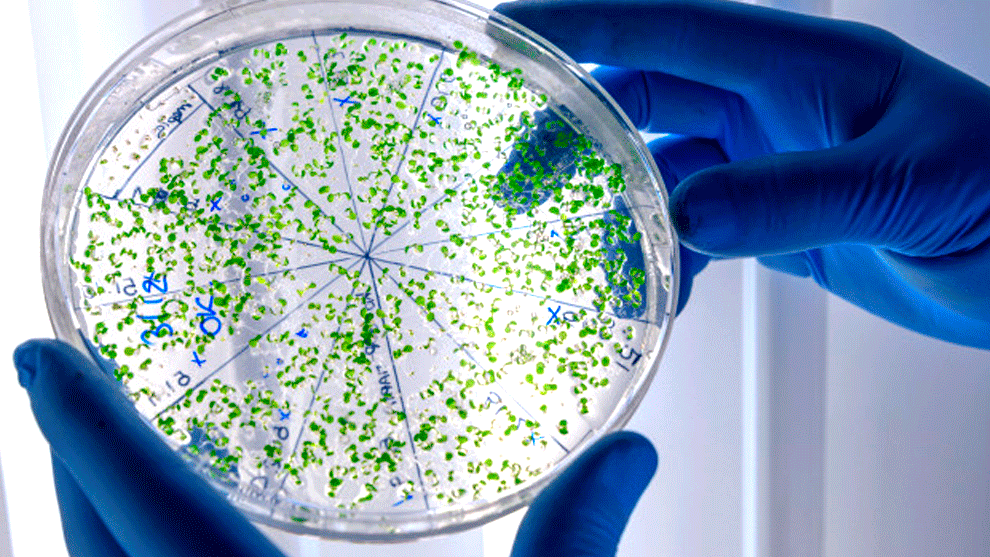
Preocupación por fenómeno mundial considerado igual de peligroso a una pandemia

OMS alerta por fenómeno mundial considerado igual de peligroso a una pandemia
Dicho fenómeno dificulta el tratamiento de infecciones comunes y aumenta el riesgo de propagación de enfermedades, formas graves de infección y muerte.
Noticias RCN
01:13 p. m.
El fenómeno mundial de la resistencia antimicrobiana, tan peligroso como una pandemia, amenaza con destruir un siglo de progreso médico, alertó a la Organización Mundial de la Salud (OMS) el viernes.
La resistencia a los antimicrobianos se produce cuando las bacterias, los virus, los hongos y los parásitos son resistentes a los efectos de los medicamentos, incluidos los antibióticos, lo que dificulta el tratamiento de las infecciones comunes y aumenta el riesgo de propagación de enfermedades, formas graves de infección y muerte.
Le puede interesar: Ocho claves para entender los ensayos de la vacuna contra el covid-19
Con motivo de la Semana Mundial de los Antimicrobianos (de 18 al 24 de noviembre), la OMS, en colaboración con la Organización de las Naciones Unidas para la Agricultura y la Alimentación (FAO) y la Organización Mundial de Sanidad Animal (OIE), lanzó el viernes un grupo de alto nivel "encargado de combatir la crisis que se acelera de la resistencia a los medicamentos".
Sus dos copresidentas son la primera ministra de Bangladés, Sheikh Hasina, y su homóloga de Barbados, Mia Mottley.
Este grupo reunirá a jefes de Estado, ministros y dirigentes de empresas y organizaciones de la sociedad civil. "La resistencia a los antimicrobianos no parece tan urgente como una pandemia, pero es igualmente peligrosa", afirmó el jefe de la OMS, Tedros Adhanom Ghebreyesus, en una conferencia de prensa.
Lea además: ¿Por qué el tapabocas no es tan efectivo para prevenir el covid-19, según estudio danés?
La resistencia a los antimicrobianos es "una de las mayores amenazas para la salud de nuestro tiempo" que "podría destruir un siglo de progresos médicos y nos deja indefensos frente a infecciones que hoy pueden ser tratadas fácilmente", advirtió.
Los antimicrobianos son armas esenciales para luchar contra las enfermedades en los seres humanos, los animales y las plantas. Incluyen antibióticos, antivirales, antifúngicos y antiparasitarios.





